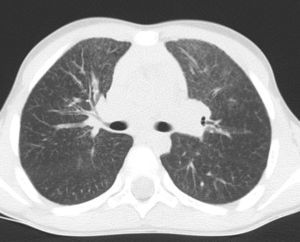
Chest CT scan repeated years later (twin number 1).

We present the case of two twin brothers with surfactant protein C deficiency who were treated with hydroxychloroquine for three years, with apparent success. The exact physiopathology of this disease is not known and there is no specific treatment for it. There is merely news from a few previous descriptions in the literature about the use of hydroxychloroquine for surfactant protein C deficiency with satisfactory results. Two years after the treatment was withdrawn, the twins were evaluated once again: they presented no new infections, growth and general state were normal and chest CT showed a notable additional reduction in the interstitial pneumopathy. These data seem to cast some doubt on the efficacy of hydroxychloroquine, and they suggest that the clinical improvement was simply the natural evolution of the disease.
Presentamos el caso de dos hermanos gemelos con déficit de proteína C surfactante que fueron tratados mediante el empleo de hidroxicloroquina durante tres años, con aparente éxito. La fisiopatología exacta de esta enfermedad no se conoce, y no disponemos de ningún tratamiento específico para ella; tan solo tenemos noticia de unas pocas descripciones previas en la literatura sobre el uso de hidroxicloroquina para el déficit de proteína C surfactante con resultados satisfactorios. Dos años después de la retirada del tratamiento se volvió a evaluar a los gemelos: no presentaron nuevas infecciones, el crecimiento y el estado general fueron normales, y la TC de tórax mostró una notable reducción adicional de la neumopatía intersticial. Estos datos parecen poner en duda la eficacia de la hidroxicloroquina, y sugieren que la mejoría clínica fue simplemente la evolución natural de la enfermedad.
Surfactant protein C deficiency is characterised by deficiency of the protein and its intracellular accumulation, with subsequent local inflammation and interstitial lung disease. There is no specific treatment, but hydroxychloroquine has been reported to be effective.
We describe the case of twin brothers with surfactant protein C deficiency who presented recurrent episodes of respiratory distress. They were treated with hydroxychloroquine for three years, after which the treatment was withdrawn without any further recurrences.
Case PresentationMonozygotic twin brothers were born at 31 weeks gestation, with birth weights of 1490 and 1710g. Their mother received prophylaxis with corticoids for hyaline membrane disease.
The first few months were characterised by failure to thrive and, starting from 7 months of age, by recurrent episodes of respiratory distress, with cough, fever, wheezing, tachydyspnoea and desaturation with bilateral crackles. Chest X-rays showed acute interstitial involvement. During the first year, one of the twins was hospitalised on four occasions (two of which required tracheal intubation) and the other on three (one requiring intubation). On each admission, they were treated with oxygen, antibiotics, corticoids and bronchodilators. Tracheal tube aspirate cultures and tests for cytomegalovirus, Pneumocystis and Mycoplasma were negative. Cystic fibrosis, Schwachmann's disease, malabsorption, immunodeficiency and pulmonary hypertension were ruled out.
In the following two years, the patients had experienced three less severe episodes each year. Between episodes, physical examination showed moderate tachypnoea at rest (respiratory rate 45/min), with 97% oxygen saturation of room air. Physical examination showed progressive digital clubbing and chest deformities with flattening of the anteroposterior diameter.
At the age of 30 months (when the last episode had occurred 2 months previously), a chest X-ray was obtained during a stable period of good health in the twin with the more severe clinical history, and persistent interstitial-alveolar involvement was observed; a high resolution CT scan (HRCT) revealed ground-glass opacification of the image, with an interstitial pattern and fine nodules (Fig. 1).
Since the form of clinical presentation was similar in both the brothers, with similar observations on the chest X-ray, a diagnosis of surfactant protein C deficiency was suspected: lung biopsy showed the presence of alveolar cholesterol granulomas and lymphocyte and macrophage infiltrates. Genetic analysis showed a de novo mutation in the pulmonary surfactant-associated protein C (SFTPC) gene (amino acid substitution I73T).
Treatment was initiated with oral hydroxychloroquine (10mg/kg/day) at 3 years of age, with prednisone for the first 3 months (2mg/kg/day for the first month and then a gradual reduction until discontinuation).
With the initiation of treatment, there was only one episode of upper respiratory tract infection (with no respiratory distress), which did not require hospitalisation and was treated at home using oral antibiotics (Fig. 2).
The twins did not have any drug-induced adverse effects and recovered normal height and weight (Fig. 3). After 18 months of treatment, the family moved to another city and no further follow-up examinations were carried out.
After four years, the family returned and requested a re-evaluation. Two years earlier, the parents had stopped treatment of their own accord (it had been maintained continually for a total of 3 years and 6 months).
After discontinuation of treatment, the twins did not present any notable episodes of lung infection and enjoyed normal growth. The physical examination was normal, as was the saturometry. At the age of 9, HRCT was repeated in the twin who had the more severe clinical history, observing a reduction in the interstitial lung disease (Fig. 4). Spirometry was performed in both the brothers, giving age-appropriate results.
DiscussionSurfactant protein C deficiency is a very common autosomal dominant disease characterised by a deficiency of the protein and its intracellular accumulation,1 and is associated with acute respiratory failure and interstitial lung disease.2 Mutation I73T is one of the most common mutations in SFTPC.3 Clinical presentation ranges from respiratory distress immediately after birth to failure to thrive and progressive onset of respiratory failure at older ages. The age of onset, severity of the disease and natural evolution of the disorder show differences even within the same family with the same mutation.4
There is no specific treatment. The evidence indicating intracellular accumulation of a protein with a structural defect, with subsequent local inflammation, suggested the use of anti-inflammatory drugs.
The efficacy of oral hydroxychloroquine has been described, alone or combined with corticoids.3,5,6 To our knowledge, the question of the appropriate duration of treatment has not been addressed in this context. In these two patients, there was an apparent response to treatment, which was discontinued after 3 years. Two years after withdrawing the medication, they remained well, with no clinical or radiological signs of relapse.
These data seem to cast doubt on the efficacy of hydroxychloroquine. The fact that there was no worsening of the disease after discontinuing treatment clearly suggests that the clinical improvement was simply the natural evolution of the disease.
Even considering potential treatment efficacy, this experience suggests at least the possibility of stopping treatment at a certain point, thereby limiting the side effects of a medication that may be toxic. The most common side effects consist of gastrointestinal disturbances, skin rash and headache; ocular toxicity is very rare but may lead to irreversible retinopathy.7
At present, very little is known about the prevalence, pathophysiology and evolution of the disease associated with surfactant protein C deficiency. We hope that these types of reports provide a basis for the design and conduct of multicentre studies that clearly establish the measures that should be taken for the diagnosis and treatment of these patients.
Please cite this article as: Rabach I, et al. ¿Es eficaz el tratamiento con hidroxicloroquina en el déficit de proteína C surfactante? Arch Bronconeumol. 2013; 49:213-5.